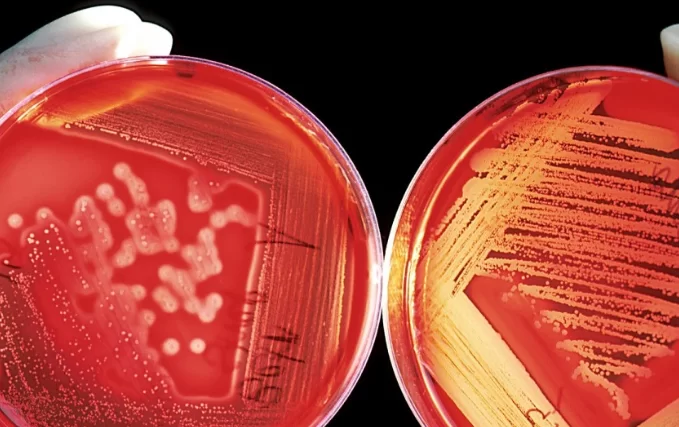
Бурятские учёные создали «космический полимер», не поддающийся радиации

Бурятские учёные создали «космический полимер», не поддающийся радиации
Учёные из Байкальского института природопользования СО РАН в Улан-Удэ совместно с коллегами из Курчатовского института и Сеченовского университета разработали новый высокотемпературный полимер с памятью формы на основе бензимидазолов, предназначенный для использования в космических технологиях. Материал получил название C8-PBI и отличается уникальной устойчивостью к жёсткому радиационному воздействию.

Эксперименты показали, что после интенсивного гамма-облучения полимер практически не теряет своих эксплуатационных характеристик. Механическая прочность материала осталась на уровне необлучённых образцов, а коэффициенты фиксации и восстановления формы превышают 89% от контрольных значений, отмечают в телеграм-канале «Кругобайкальская наука».
Благодаря этим свойствам C8-PBI рассматривается как перспективный материал для космических конструкций. Он может применяться при создании развёртываемых элементов, антенн, механизмов и других деталей, которые должны надёжно функционировать в условиях радиационного излучения.
Результаты работы опубликованы в международном журнале Polymer Degradation and Stability. Исследование проводилось химиками Лаборатории химии полимеров Байкальского института природопользования СО РАН и открывает новые возможности для использования высокотемпературных полимеров в космической отрасли.
Эксперименты показали, что после интенсивного гамма-облучения полимер практически не теряет своих эксплуатационных характеристик. Механическая прочность материала осталась на уровне необлучённых образцов, а коэффициенты фиксации и восстановления формы превышают 89% от контрольных значений, отмечают в телеграм-канале «Кругобайкальская наука».
Благодаря этим свойствам C8-PBI рассматривается как перспективный материал для космических конструкций. Он может применяться при создании развёртываемых элементов, антенн, механизмов и других деталей, которые должны надёжно функционировать в условиях радиационного излучения.
Результаты работы опубликованы в международном журнале Polymer Degradation and Stability. Исследование проводилось химиками Лаборатории химии полимеров Байкальского института природопользования СО РАН и открывает новые возможности для использования высокотемпературных полимеров в космической отрасли.
Читайте также:
Ctrl
Enter
Заметили ошЫбку
Выделите текст и нажмите Ctrl+EnterЧитайте также: